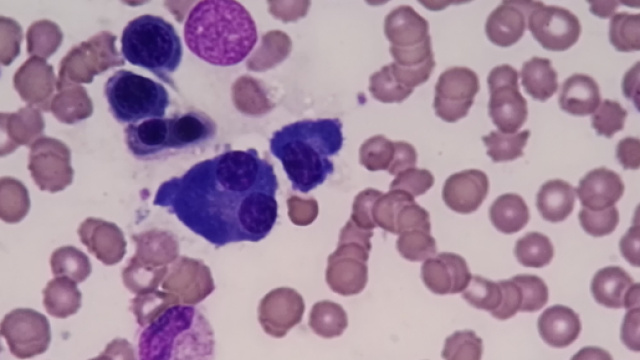
Alcuni fattori di rischio del mieloma multiplo.

Il mieloma multiplo è un tipo di tumore che colpisce le plasmacellule del sangue che difendono l'organismo da infezioni e patologie. In presenza di mieloma, le plasmacellule vengono prodotte più del dovuto e si ammassano nel midollo formando vere e proprie masse e lesioni tumorali. Ecco una lista dei principali fattori di rischio di questa forma di cancro.
L'incidenza dell'età
Il primo fattore di rischio del mieloma multiplo è l'età: questa malattia, infatti, si sviluppa prevalentemente negli anziani, in soggetti da 65 anni in su.

Il sesso maschile
Il mieloma multiplo colpisce principalmente il sesso maschile rispetto a quello femminile, quindi sono decisamente più a rischio gli uomini.

L'incidenza dell'obesità
Anche l'obesità gioca un ruolo fondamentale nello sviluppo del mieloma, in quanto causa una serie di alterazioni endocrine.

Preesistente MGUS
Inoltre, nella maggior parte dei casi, lo sviluppo del mieloma multiplo è preceduto da un'altra patologia, ossia la gammopatia monoclonale di incerto significato (MGUS) che è caratterizzata dall'accumulo nel sangue e nel midollo osseo di una proteina anomala chiamata paraproteina.

Esposizione a sostanze tossiche
Infine, un ulteriore fattore di rischio del mieloma è l'esposizione alle radiazioni e a sostanze nocive presenti nella lavorazione dell'industria del petrolio.